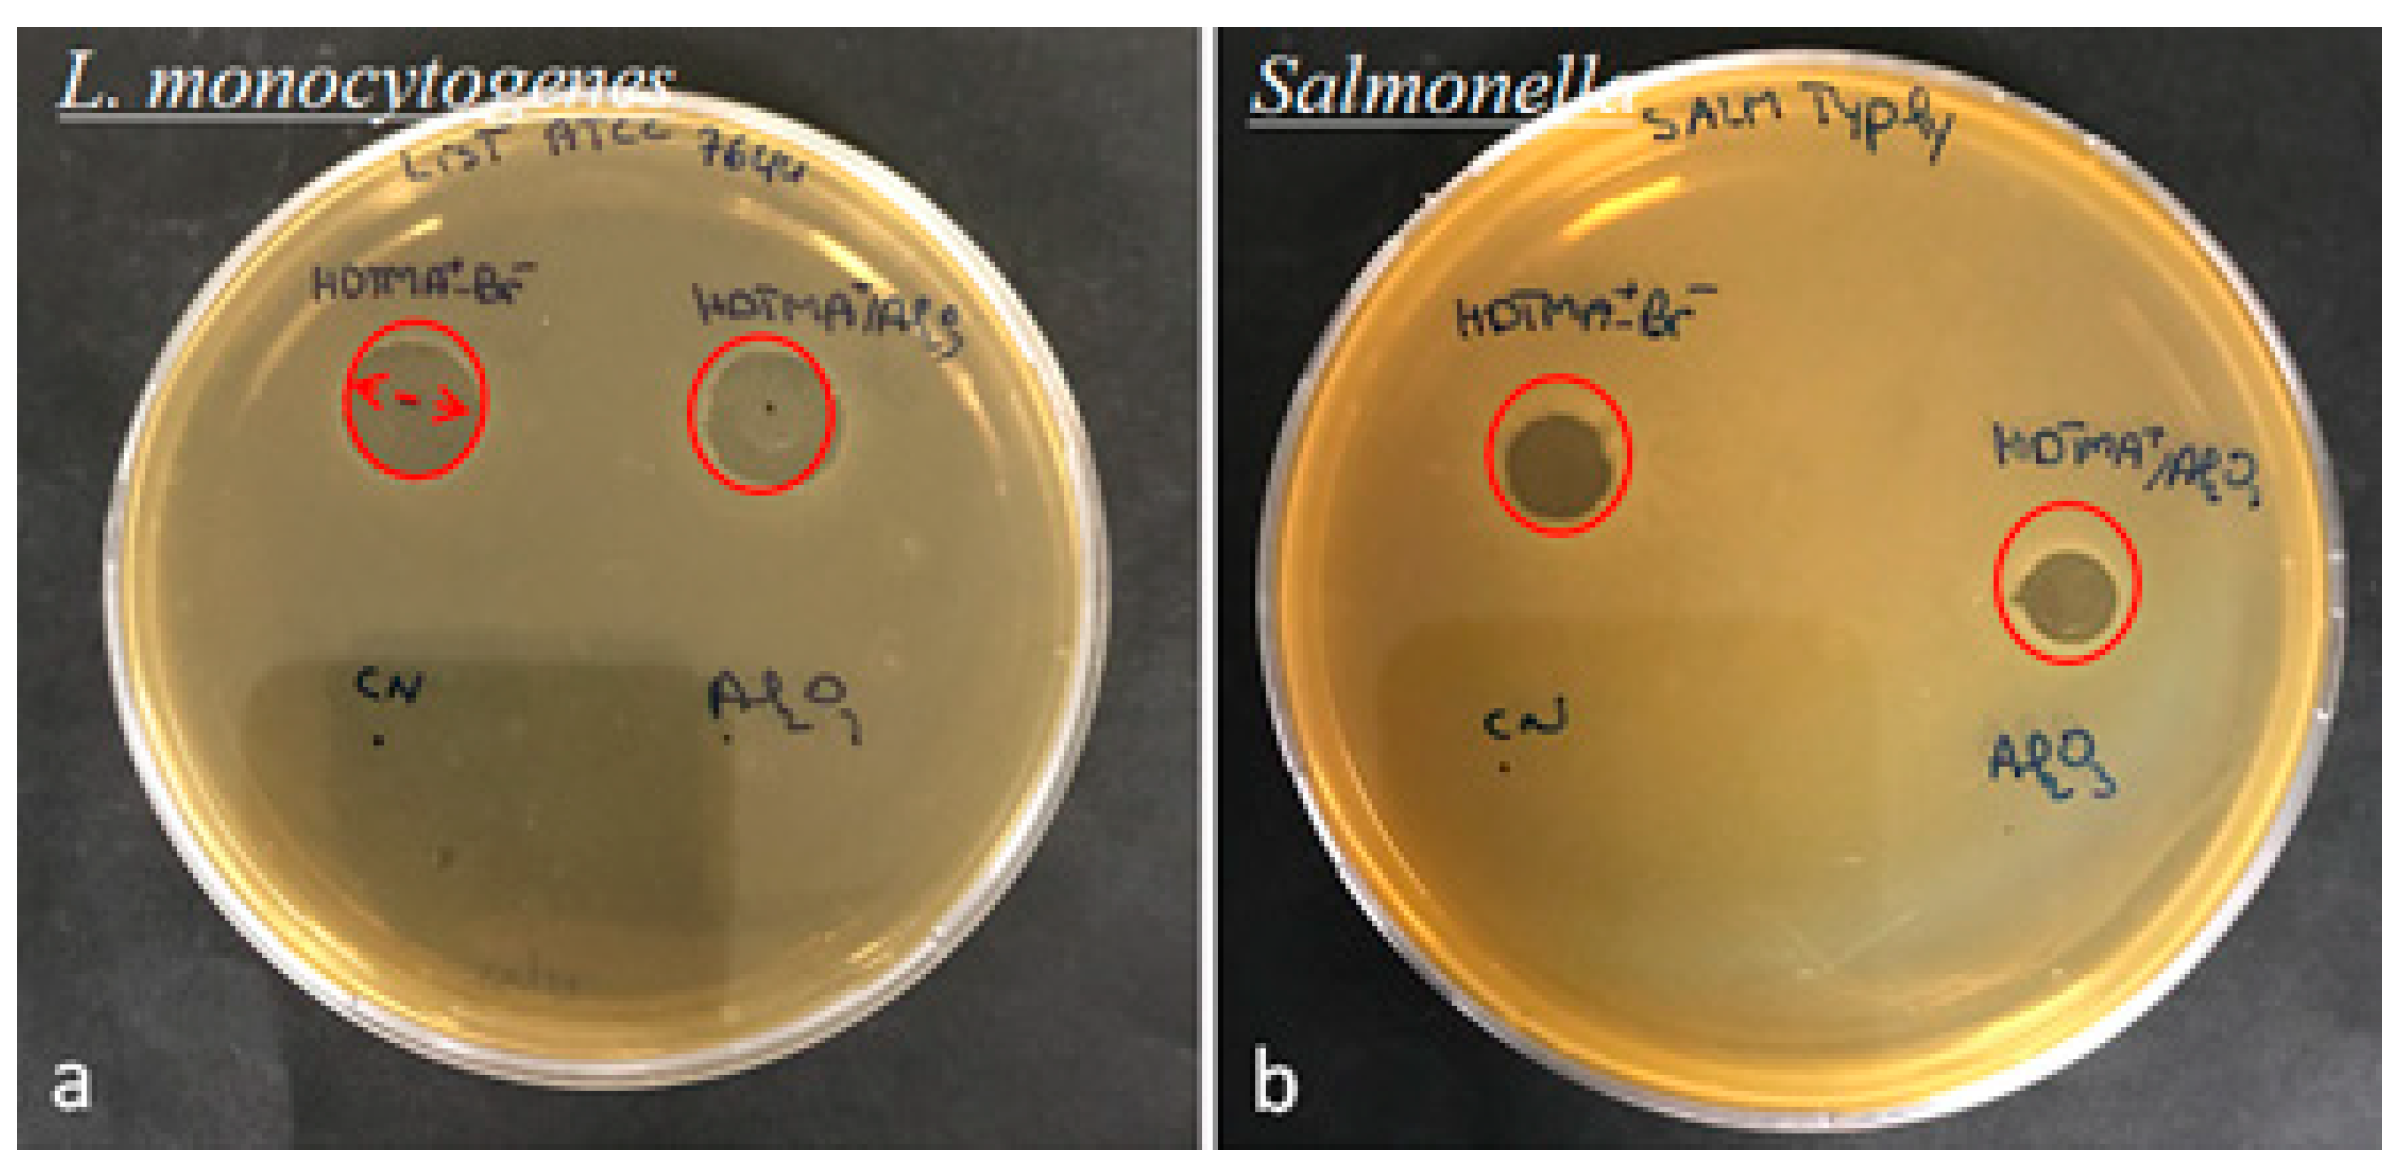
Life 12 01700 g012 Life 12 01700 g012

Study of the Effectiveness of Alumina and HDTMA/Alumina Composite in the Removal of Para-Nitrophenol and the Deactivation of Bacterial Effect of Listeria monocytogenes and Salmonella spp.
Abstract
1. Introduction
2. Materials and Methods
2.1. Material
2.2. Preparation of HDTMA+(xM)/Al2O3 Composite
2.3. Characterization
- -
- Fourier transform infrared spectra (FTIR) were collected from 400 to 4000 cm−1 at a resolution of 4 cm−1 on an FTIR spectrometer (Shimadzu, JASCO 4100) using a KBr pellet technique. The samples were first ground and then mixed with KBr at a w/w: 4/96 ratio of (sample/KBr).
- -
- UV/Visible spectra of fine powder samples of Al2O3 and HDTMA+/Al2O3 composite and p-NP solutions were recorded using a JASCO V-750 spectrophotometer equipped with an integrating sphere using quartz window, whereas, p-NP in the solutions, which reach a maximum absorption band at λ = 396 nm, was quantified during the adsorption experiments using a standard quartz cuvette.
- -
- Differential scanning calorimetry measurements (DSC) of samples were performed using a DSC 131 Evo instrument and thermogravimetric analysis (TGA) was carried out with Shimadzu TA 60 instrument in the same experimental conditions. Samples were placed in alumina cup and then heated at 20 °C/min from room temperature to 600 °C under air atmosphere. The corresponding empty cup of alumina was used as reference. Heat flux and mass loss are recorded as a function of degradation temperature.
2.4. Method
2.4.1. Kinetics and Isotherms
2.4.2. Antibacterial Activity
Disc Diffusion Method
Microdilution Method
| Kinetic Models | Ref | |
|---|---|---|
| Pseudo-first order | [30] | |
| Pseudo-second order | [31] | |
| Weber and Morris | [32] | |
| Isotherms models | ||
| Langmuir | [33] | |
| Freundlich | [34] | |
| Redlich-Peterson | [35] | |
| Thermodynamic equations | ||
| Activation energy | ||
| Standard thermodynamic parameters | [36] | |
| Error functions | ||
| SD: Normalized standard deviation | [37,38] | |
| χ2: Chi-square analysis | ||
| R2: Coefficient of determination | ||
2.5. Determination of the Point of Zero Charge: Pzc
3. Results and Discussion
3.1. Characterization of the Adsorbents
3.1.1. UV/Visible
3.1.2. Thermogravimetric Analysis: TGA/DrTGA
3.1.3. DSC
3.1.4. Point of Zero Charge
3.2. Adsorption Kinetics
3.3. Adsorption Isotherm
3.4. Thermodynamic Study of p-NP Adsorption
3.5. Adsorption Mechanism
3.6. Antibacterial Activities
4. Conclusions
Author Contributions
Funding
Institutional Review Board Statement
Informed Consent Statement
Data Availability Statement
Acknowledgments
Conflicts of Interest
References
- Deblonde, T.; Cossu-Leguille, C.; Hartemann, P. Emerging Pollutants in Wastewater: A Review of the Literature. Int. J. Hyg. Environ. Health 2011, 214, 442–448. [Google Scholar] [CrossRef] [PubMed]
- WHO. UNICEF Progress on Drinking Water and Sanitation-2012 Update; WHO: Geneva, Switzerland, 2012. [Google Scholar]
- Aditya, T.; Pal, A.; Pal, T. Nitroarene Reduction: A Trusted Model Reaction to Test Nanoparticle Catalysts. Chem. Commun. 2015, 51, 9410–9431. [Google Scholar] [CrossRef] [PubMed]
- Yi, S.; Zhuang, W.Q.; Wu, B.; Tay, S.T.L.; Tay, J.H. Biodegradation of P-Nitrophenol by Aerobic Granules in a Sequencing Batch Reactor. Environ. Sci. Technol. 2006, 40, 2396–2401. [Google Scholar] [CrossRef] [PubMed]
- Tomei, M.C.; Annesini, M.C.; Rita, S.; Daugulis, A.J. Two-Phase Partitioning Bioreactors Operating with Polymers Applied to the Removal of Substituted Phenols. Environ. Sci. Technol. 2010, 44, 7254–7259. [Google Scholar] [CrossRef]
- United States Public Health Service, Toxicological Profile of Nitrophenols; Agency for Toxic Substances and Disease Registry: Atlanta, GA, USA, 1992.
- Red, E.D. Pesticides and Toxic Substances Certified Mail; United States Environmental Protection Agency Office of Prevention: Washington, DC, USA, 1998.
- Nakhjiri, M.T.; Bagheri Marandi, G.; Kurdtabar, M. Preparation of Magnetic Double Network Nanocomposite Hydrogel for Adsorption of Phenol and P-Nitrophenol from Aqueous Solution. J. Environ. Chem. Eng. 2021, 9, 105039. [Google Scholar] [CrossRef]
- Liu, L.; Deng, G.; Shi, X. Adsorption Characteristics and Mechanism of P-Nitrophenol by Pine Sawdust Biochar Samples Produced at Different Pyrolysis Temperatures. Sci. Rep. 2020, 10, 5149. [Google Scholar] [CrossRef]
- Pourkhanali, K.; Saleh, M.; Khayati, G. Performance Evaluation of Bulk Liquid Membrane Technique on P-Nitrophenol Removal from Aqueous Solution. Chem. Biochem. Eng. Q. 2018, 32, 83–90. [Google Scholar] [CrossRef]
- Suja, E.; Nancharaiah, Y.V.; Venugopalan, V.P. P-Nitrophenol Biodegradation by Aerobic Microbial Granules. Appl. Biochem. Biotechnol. 2012, 167, 1569–1577. [Google Scholar] [CrossRef]
- Aazza, M.; Ahlafi, H.; Moussout, H.; Mounir, C.; Fadel, A.; Addad, A. Catalytic Reduction of Nitro-Phenolic Compounds over Ag, Ni and Co Nanoparticles Catalysts Supported on γ-Al2O3. J. Environ. Chem. Eng. 2020, 8, 103707. [Google Scholar] [CrossRef]
- Gee, J.C.; Fulbright, K.W. Simultaneous Determination of Adsorption Coefficients and Surface Reaction Mechanisms Using Initial Reaction Rates. React. Kinet. Mech. Catal. 2021, 134, 1–21. [Google Scholar] [CrossRef]
- Aazza, M.; Ahlafi, H.; Moussout, H.; Maghat, H. Ortho-Nitro-Phenol Adsorption onto Alumina and Surfactant Modified Alumina: Kinetic, Isotherm and Mechanism. J. Environ. Chem. Eng. 2017, 5, 3418–3428. [Google Scholar] [CrossRef]
- Aazza, M.; Ahlafi, H.; Moussout, H.; Maghat, H. Adsorption of Metha-Nitrophenol onto Alumina and HDTMA Modified Alumina: Kinetic, Isotherm and Mechanism Investigations. J. Mol. Liq. 2018, 268, 587–597. [Google Scholar] [CrossRef]
- Zermane, F.; Bouras, O.; Baudu, M.; Basly, J.P. Cooperative Coadsorption of 4-Nitrophenol and Basic Yellow 28 Dye onto an Iron Organo-Inorgano Pillared Montmorillonite Clay. J. Colloid Interface Sci. 2010, 350, 315–319. [Google Scholar] [CrossRef] [PubMed]
- Attia, A.A.; Girgis, B.S.; Khedr, S.A. Capacity of Activated Carbon Derived from Pistachio Shells by H3PO4 in the Removal of Dyes and Phenolics. J. Chem. Technol. Biotechnol. 2003, 78, 611–619. [Google Scholar] [CrossRef]
- Elizalde-González, M.P.; Peláez-cid, A.A. Removal of Textile Dyes from Aqueous Solutions by Adsorption on Biodegradable Wastes. Environ. Technol. 2003, 24, 821–829. [Google Scholar] [CrossRef] [PubMed]
- Wawrzkiewicz, M.; Hubicki, Z. Kinetics of Adsorption of Sulphonated Azo Dyes on Strong Basic Anion Exchangers. Environ. Technol. 2009, 30, 1059–1071. [Google Scholar] [CrossRef]
- O’Mahony, T.; Guibal, E.; Tobin, J.M. Reactive Dye Biosorption by Rhizopus Arrhizus Biomass. Enzym. Microb. Technol. 2002, 31, 456–463. [Google Scholar] [CrossRef]
- Ayranci, E.; Conway, B.E. Removal of Phenol, Phenoxide and Chlorophenols from Waste-Waters by Adsorption and Electrosorption at High-Area Carbon Felt Electrodes. J. Electroanal. Chem. 2001, 513, 100–110. [Google Scholar] [CrossRef]
- Tang, D.; Zheng, Z.; Lin, K.; Luan, J.; Zhang, J. Adsorption of P-Nitrophenol from Aqueous Solutions onto Activated Carbon Fiber. J. Hazard. Mater. 2007, 143, 49–56. [Google Scholar] [CrossRef]
- El Ouardi, M.; Laabd, M.; Abou Oualid, H.; Brahmi, Y.; Abaamrane, A.; Elouahli, A.; Ait Addi, A.; Laknifli, A. Efficient Removal of P-Nitrophenol from Water Using Montmorillonite Clay: Insights into the Adsorption Mechanism, Process Optimization, and Regeneration. Environ. Sci. Pollut. Res. 2019, 26, 19615–19631. [Google Scholar] [CrossRef]
- Zbair, M.; Anfar, Z.; Ahsaine, H.A. Reusable Bentonite Clay: Modelling and Optimization of Hazardous Lead and p-Nitrophenol Adsorption Using a Response Surface Methodology Approach. RSC Adv. 2019, 9, 5756–5769. [Google Scholar] [CrossRef] [PubMed]
- Zhang, L.; Yang, H.; Zhang, H. Hyper-Crosslinked Dicationic Ionic Liquid Porous Polymers for Nitrophenol Adsorption. Microporous Mesoporous Mater. 2022, 342, 112118. [Google Scholar] [CrossRef]
- Ngulube, T.; Gumbo, J.R.; Masindi, V.; Maity, A. An Update on Synthetic Dyes Adsorption onto Clay Based Minerals: A State-of-Art Review. J. Environ. Manag. 2017, 191, 35–57. [Google Scholar] [CrossRef] [PubMed]
- Ewis, D.; Ba-Abbad, M.M.; Benamor, A.; El-Naas, M.H. Adsorption of Organic Water Pollutants by Clays and Clay Minerals Composites: A Comprehensive Review. Appl. Clay Sci. 2022, 229, 106686. [Google Scholar] [CrossRef]
- Al Mamun, M.; Turin, T.C. Safety of Street Foods. In Food Hygiene and Toxicology in Ready-to-Eat Foods; Academic Press: Cambridge, MA, USA, 2016; pp. 15–29. ISBN 9780128020081. [Google Scholar]
- Bouymajane, A.; Filali, F.R.; El Majdoub, Y.O.; Ouadik, M.; Abdelilah, R.; Cavò, E.; Miceli, N.; Taviano, M.F.; Mondello, L.; Cacciola, F. Phenolic Compounds, Antioxidant and Antibacterial Activities of Extracts from Aerial Parts of Thymus Zygis Subsp. Gracilis, Mentha Suaveolens and Sideritis Incana from Morocco. Chem. Biodivers. 2022, 19, 18. [Google Scholar] [CrossRef]
- Lagergren, B.K.S. Svenska Zur Theorie Der Sogenannten Adsorption Geloster Stofe, Kungliga Svenska Vetenskapsakademiens. Handlingar 1989, 24, 1–39. [Google Scholar]
- Ho, Y.S.; McKay, G. Sorption of Dye from Aqueous Solution by Peat. Chem. Eng. J. 1998, 70, 115–124. [Google Scholar] [CrossRef]
- Kannan, N.; Meenakshisundaram, M. Adsorption of Congo Red on Various Activated Carbons. Water Air. Soil Pollut. 2002, 138, 289–305. [Google Scholar] [CrossRef]
- Langmuir, I. The Adsorption of Gases on Plane Surfaces of Glass, Mica and Platinum. J. Am. Chem. Soc. 1918, 40, 1361–1403. [Google Scholar] [CrossRef]
- Freundlich, H.; Heller, W. The Adsorption of Cis- and Trans-Azobenzene. J. Am. Chem. Soc. 1939, 61, 2228–2230. [Google Scholar] [CrossRef]
- Aksu, Z.; Yener, J. The Usage of Dried Activated Sludge and Fly Ash Wastes in Phenol Biosorption/Adsorption: Comparison with Granular Activated Carbon. J. Environ. Sci. Heal. Part A Toxic/Hazard. Subst. Environ. Eng. 1999, 34, 1777–1796. [Google Scholar] [CrossRef]
- Özbay, I.; Özdemir, U.; Özbay, B.; Veli, S. Kinetic, Thermodynamic, and Equilibrium Studies for Adsorption of Azo Reactive Dye onto a Novel Waste Adsorbent: Charcoal Ash. Desalin. Water Treat. 2013, 51, 6091–6100. [Google Scholar] [CrossRef]
- Tran, H.N.; You, S.J.; Chao, H.P. Effect of Pyrolysis Temperatures and Times on the Adsorption of Cadmium onto Orange Peel Derived Biochar. Waste Manag. Res. 2016, 34, 129–138. [Google Scholar] [CrossRef]
- Tran, H.N.; Wang, Y.F.; You, S.J.; Chao, H.P. Insights into the Mechanism of Cationic Dye Adsorption on Activated Charcoal: The Importance of Π–Π Interactions. Process Saf. Environ. Prot. 2017, 107, 168–180. [Google Scholar] [CrossRef]
- Thomas, F.; Rakotonarivo, E.; Bottero, J.-Y. La Charge de Surface Des Solides Divisés: Origine, Mesure et Modélisation./The Surface Charge of Divided Solids: Origin, Measurement and Modeling. Sci. Géologiques. Bull. 1993, 46, 217–227. [Google Scholar] [CrossRef]
- Li, Z.; Jiang, W.T. A Thermogravimetric Investigation of Alkylammonium Intercalation into Rectorite. Thermochim. Acta 2009, 483, 58–65. [Google Scholar] [CrossRef]
- Debczak, A.; Ryczkowski, J.; Patkowski, J. Adsorption of Biodegradable Chelating Compounds on Inorganic Oxides. Appl. Surf. Sci. 2010, 256, 5449–5452. [Google Scholar] [CrossRef]
- Wiśniewska, M.; Chibowski, S.; Urban, T. Influence of Temperature on Adsorption Mechanism of Anionic Polyacrylamide in the Al2O3 -Aqueous Solution System. Fluid Phase Equilib. 2016, 408, 205–211. [Google Scholar] [CrossRef]
- Haydar, S.; Ferro-García, M.A.; Rivera-Utrilla, J.; Joly, J.P. Adsorption of P-Nitrophenol on an Activated Carbon with Different Oxidations. Carbon N. Y. 2003, 41, 387–395. [Google Scholar] [CrossRef]
- Kupeta, A.J.K.; Naidoo, E.B.; Ofomaja, A.E. Kinetics and Equilibrium Study of 2-Nitrophenol Adsorption onto Polyurethane Cross-Linked Pine Cone Biomass. J. Clean. Prod. 2018, 179, 191–209. [Google Scholar] [CrossRef]
- Lv, G.; Liu, J.; Xiong, Z.; Zhang, Z.; Guan, Z. Selectivity Adsorptive Mechanism of Different Nitrophenols on UIO-66 and UIO-66-NH2in Aqueous Solution. J. Chem. Eng. Data 2016, 61, 3868–3876. [Google Scholar] [CrossRef]
- Koubaissy, B.; Joly, G.; Magnoux, P. Adsorption and Competitive Adsorption on Zeolites of Nitrophenol Compounds Present in Wastewater. Ind. Eng. Chem. Res. 2008, 47, 9558–9565. [Google Scholar] [CrossRef]
- Wu, Z.; Yuan, X.; Zhong, H.; Wang, H.; Zeng, G.; Chen, X.; Wang, H.; Zhang, L.; Shao, J. Enhanced Adsorptive Removal of P-Nitrophenol from Water by Aluminum Metal-Organic Framework/Reduced Graphene Oxide Composite. Sci. Rep. 2016, 6, 25638. [Google Scholar] [CrossRef]
- Zhang, B.; Li, F.; Wu, T.; Sun, D.; Li, Y. Adsorption of P-Nitrophenol from Aqueous Solutions Using Nanographite Oxide. Colloids Surf. A Physicochem. Eng. Asp. 2015, 464, 78–88. [Google Scholar] [CrossRef]
- Khan, D.; Kuntail, J.; Sinha, I. Mechanism of Phenol and P-Nitrophenol Adsorption on Kaolinite Surface in Aqueous Medium: A Molecular Dynamics Study. J. Mol. Graph. Model. 2022, 116, 108251. [Google Scholar] [CrossRef]
- Gil, A.; Assis, F.C.C.; Albeniz, S.; Korili, S.A. Removal of Dyes from Wastewaters by Adsorption on Pillared Clays. Chem. Eng. J. 2011, 168, 1032–1040. [Google Scholar] [CrossRef]
- Ho, Y.S. Selection of Optimum Sorption Isotherm. Carbon N. Y. 2004, 42, 2115–2116. [Google Scholar] [CrossRef]
- Frost, R.L.; Zhou, Q.; He, H.; Xi, Y. An Infrared Study of Adsorption of Para-Nitrophenol on Mono-, Di- and Tri-Alkyl Surfactant Intercalated Organoclays. Spectrochim. Acta Part A Mol. Biomol. Spectrosc. 2008, 69, 239–244. [Google Scholar] [CrossRef][Green Version]
- Gu, L.; Xu, J.; Lv, L.; Liu, B.; Zhang, H.; Yu, X.; Luo, Z. Dissolved Organic Nitrogen (DON) Adsorption by Using Al-Pillared Bentonite. Desalination 2011, 269, 206–213. [Google Scholar] [CrossRef]
- Liu, B.; Yang, F.; Zou, Y.; Peng, Y. Adsorption of Phenol and p -Nitrophenol from Aqueous Solutions on Metal-Organic Frameworks: Effect of Hydrogen Bonding. J. Chem. Eng. Data 2014, 59, 1476–1482. [Google Scholar] [CrossRef]
- Bala, T.; Armstrong, G.; Laffir, F.; Thornton, R. Titania-Silver and Alumina-Silver Composite Nanoparticles: Novel, Versatile Synthesis, Reaction Mechanism and Potential Antimicrobial Application. J. Colloid Interface Sci. 2011, 356, 395–403. [Google Scholar] [CrossRef] [PubMed]
- Borker, P.; Desai Gaokar, R. Enhanced Photocatalytic Activity of ZnO Supported on Alumina and Antibacterial Study. Surf. Interfaces 2020, 19, 100477. [Google Scholar] [CrossRef]
- Zavareh, S.; Zarei, M.; Darvishi, F.; Azizi, H. As(III) Adsorption and Antimicrobial Properties of Cu-Chitosan/Alumina Nanocomposite. Chem. Eng. J. 2015, 273, 610–621. [Google Scholar] [CrossRef]
- Qi, L.; Xu, Z.; Jiang, X.; Hu, C.; Zou, X. Preparation and Antibacterial Activity of Chitosan Nanoparticles. Carbohydr. Res. 2004, 339, 2693–2700. [Google Scholar] [CrossRef]
- Lu, G.; Wu, D.; Fu, R. Studies on the Synthesis and Antibacterial Activities of Polymeric Quaternary Ammonium Salts from Dimethylaminoethyl Methacrylate. React. Funct. Polym. 2007, 67, 355–366. [Google Scholar] [CrossRef]
- Zhang, A.; Liu, Q.; Lei, Y.; Hong, S.; Lin, Y. Synthesis and Antimicrobial Activities of Acrylamide Polymers Containing Quaternary Ammonium Salts on Bacteria and Phytopathogenic Fungi. React. Funct. Polym. 2015, 88, 39–46. [Google Scholar] [CrossRef]
- Sharma, N.; Jandaik, S.; Kumar, S.; Chitkara, M.; Sandhu, I.S. Synthesis, Characterisation and Antimicrobial Activity of Manganese- and Iron-Doped Zinc Oxide Nanoparticles. J. Exp. Nanosci. 2016, 11, 54–71. [Google Scholar] [CrossRef]
- Sakwises, L.; Pisitsak, P.; Manuspiya, H.; Ummartyotin, S. Effect of Mn-Substituted SnO2 Particle toward Photocatalytic Degradation of Methylene Blue Dye. Results Phys. 2017, 7, 1751–1759. [Google Scholar] [CrossRef]

| Model | Sample | Al2O3 | HDTMA+/Al2O3 | |||||
| qexp (mg/g) | 1.480 | 1.820 | 2.000 | 2.940 | 3.150 | 3.210 | ||
| T (°C) | 25 | 35 | 25 | 35 | 25 | 35 | ||
| Lagergren | k1 (min−1) | 0.016 | 0.017 | 0.018 | 0.011 | 0.007 | 0.010 | |
| qe (mg/g) | 1.209 | 1.303 | 1.453 | 0.448 | 0.400 | 0.261 | ||
| 0.885 | 0.790 | 0.760 | 0.453 | 0.165 | 0.106 | |||
| χ2 | 0.348 | 0.526 | 0.609 | 0.608 | 0.649 | 1.121 | ||
| SD | 1.728 | 1.931 | 2.088 | 1.600 | 1.380 | 2.304 | ||
| Kannan | (min−1) | 76.943 | 80.738 | 64.605 | 2.934 | 2.538 | 2.342 | |
| qt (mg/g) | 2.121 | 2.815 | 2.878 | 2.907 | 3.063 | 3.183 | ||
| 0.988 | 0.954 | 0.943 | 0.971 | 0.930 | 0.969 | |||
| χ2 | 1.536 | 2.381 | 2.077 | 0.062 | 0.080 | 0.047 | ||
| SD | 0.793 | 0.636 | 0.500 | 0.065 | 0.055 | 0.048 | ||
| Ho et Coll | k2 (g/mg min) | 0.111 | 0.238 | 0.355 | 7.107 | 11.131 | 11.575 | |
| qe (mg/g) | 1.730 | 2.055 | 2.201 | 2.911 | 3.039 | 3.199 | ||
| 0.986 | 0.982 | 0.986 | 0.998 | 0.997 | 0.999 | |||
| χ2 | 0.005 | 0.003 | 0.002 | 2 10−5 | 2 10−4 | 2 10−6 | ||
| SD | 0.060 | 0.050 | 0.040 | 0.004 | 0.010 | 0.001 | ||
| Weber et Morris | Step 1 | kd1 (mg/g)min−1 | 0.137 | 0.183 | 0.203 | 0.498 | 0.544 | 0.554 |
| Ci | 0.008 | 0.009 | 0.007 | 0.306 | 0.348 | 0.382 | ||
| 0.966 | 0.964 | 0.967 | 0.860 | 0.846 | 0.837 | |||
| SD | 0.013 | 0.018 | 0.019 | 0.113 | 0.130 | 0.137 | ||
| Step 2 | kd2 (mg/g)min−1 | 0.021 | 0.016 | 0.013 | 0.013 | 0.011 | 0.012 | |
| C2 | 1.116 | 1.521 | 1.733 | 2.657 | 2.837 | 2.967 | ||
| 0.775 | 0.340 | 0.221 | 0.195 | 0.001 | 0.213 | |||
| SD | 0.005 | 0.009 | 0.009 | 0.009 | 0.011 | 0.007 | ||
| Sample | Al2O3 | HDTMA+/Al2O3 | |||||
|---|---|---|---|---|---|---|---|
| Model | T (°C) | 25 | 35 | 45 | 25 | 35 | 45 |
| Langmuir | qm (mg/g) | 6.186 | 4.032 | 3.929 | 12.690 | 9.966 | 8.919 |
| KL (L/mg) | 0.015 | 0.041 | 0.063 | 0.020 | 0.030 | 0.037 | |
| R2 | 0.967 | 0.958 | 0.977 | 0.969 | 0.962 | 0.958 | |
| χ2 | 0.019 | 0.023 | 0.018 | 0.022 | 0.026 | 0.023 | |
| Freundlich | KF (mg/g) | 0.101 | 0.213 | 0.33 | 0.292 | 0.369 | 0.416 |
| 1/n | 0.878 | 0.721 | 0.646 | 0.841 | 0.776 | 0.740 | |
| R2 | 0.955 | 0.933 | 0.955 | 0.953 | 0.937 | 0.928 | |
| χ2 | 0.022 | 0.015 | 0.024 | 0.014 | 0.023 | 0.012 | |
| Redlich-Peterson | KR-P | 2 10−5 | 4 10−6 | 5 10−4 | 1 10−4 | 7 10−7 | 1 10−10 |
| AR-P | 0.087 | 0.120 | 0.185 | 0.253 | 0.246 | 0.267 | |
| α | 3.222 | 3.898 | 2.47 | 0.262 | 0.426 | 0.721 | |
| R2 | 0.991 | 0.972 | 0.989 | 0.969 | 0.989 | 0.992 | |
| χ2 | 0.002 | 0.005 | 0.004 | 0.014 | 0.019 | 0.012 | |
| Sample | Al2O3 | HDTMA+/Al2O3 | ||||
|---|---|---|---|---|---|---|
| T (°C) | 25 | 35 | 45 | 25 | 35 | 45 |
| Ea (kJ/mol) | 7.848 | 10.252 | ||||
| A (g.mg−1 min−1) | 2.016 | 5.180 | ||||
| R2 | 0.965 | 0.956 | ||||
| SD | 0.411 | 0.603 | ||||
| ΔG° (kJ/mol) | −0.090 | −0.285 | −0.407 | −0.727 | −1.065 | −1.261 |
| ΔS° (J/K, mol) | 15.924 | 26.839 | ||||
| ΔH° (kJ/mol) | 4.644 | 7.249 | ||||
| R2 | 0.963 | 0.942 | ||||
| SD | 0.251 | 0.4887 | ||||
| Sample | Ci (mg/mL) | Diameter of the Inhibition Zone (mm) | |||||||||||||||
|---|---|---|---|---|---|---|---|---|---|---|---|---|---|---|---|---|---|
| S1 | S2 | S3 | S4 | S5 | S6 | S7 | S8 | L1 | L2 | L3 | L4 | L5 | L6 | L7 | L8 | ||
| Al2O3 | 5 | ND | ND | ND | ND | ND | ND | ND | ND | ND | ND | ND | ND | ND | ND | ND | ND |
| HDTMA+-Br− | 5 | 22 | 24 | 19 | 22 | 23 | 18 | 17 | 21 | 18 | 16 | 16 | 16 | 14 | 20 | 16 | 17 |
| 1 | 15 | 14 | 14 | 16 | 15 | 15 | 14 | 14 | 16 | 14 | 15 | 15 | 13 | 16 | 12 | 14 | |
| 0.5 | 7 | 6 | 6 | 9 | 9 | 12 | 14 | 7 | 14 | 14 | 15 | 14 | 10 | 14 | 12 | 14 | |
| 0.1 | 8 | 11 | 10 | 9 | 9 | 13 | ND | 8 | 13 | 13 | 12 | 12 | 10 | 13 | 9 | 13 | |
| 0.05 | ND | ND | ND | ND | ND | ND | ND | ND | 9 | 11 | 13 | 10 | 9 | 10 | 9 | 11 | |
| HDTMA+/Al2O3 | 5 | 18 | 22 | 15 | 20 | 22 | 12 | 13 | 20 | 15 | 13 | 15 | 14 | 12 | 15 | 15 | 14 |
| 1 | 11 | 12 | 14 | 12 | 16 | 15 | 15 | 17 | 15 | 14 | 15 | 15 | 13 | 14 | 13 | 14 | |
| 0.5 | 8 | 9 | 8 | 9 | 8 | 15 | 10 | 6 | 13 | 11 | 14 | 12 | 10 | 12 | 11 | 11 | |
| 0.1 | 6 | 9 | 8 | 7 | 11 | 8 | ND | 8 | 12 | 11 | 12 | 12 | 9 | 11 | 9 | 11 | |
| 0.05 | ND | ND | ND | ND | ND | ND | ND | ND | 10 | 9 | 9 | 8 | 8 | 9 | 8 | 10 | |
| Sample | Ci (mg/mL) | S1 | S2 | S3 | S4 | S5 | S6 | S7 | S8 | L1 | L2 | L3 | L4 | L5 | L6 | L7 | L8 |
|---|---|---|---|---|---|---|---|---|---|---|---|---|---|---|---|---|---|
| HDTMA+-Br− | CMI | 0.1 | 0.5 | 0.1 | 0.1 | 0.1 | 0.05 | 0.1 | 0.1 | 0.01 | 0.01 | 0.05 | 0.01 | 0.05 | 0.01 | 0.05 | 0.01 |
| CMB | 0.1 | 0.5 | 0.1 | 0.1 | 0.1 | 0.05 | 0.1 | 0.1 | 0.01 | 0.01 | 0.05 | 0.01 | 0.05 | 0.01 | 0.05 | 0.01 | |
| R | 1 | 1 | 1 | 1 | 1 | 1 | 1 | 1 | 1 | 1 | 1 | 1 | 1 | 1 | 1 | 1 | |
| HDTMA+/Al2O3 | CMI | 0.1 | 0.5 | 0.1 | 0.1 | 0.5 | 0.5 | 0.1 | 0.5 | 0.01 | 0.01 | 0.01 | 0.01 | 0.5 | 0.5 | 0.01 | 0.5 |
| CMB | 0.1 | 0.5 | 0.1 | 0.1 | 0.5 | 0.5 | 0.1 | 0.5 | 0.01 | 0.01 | 0.01 | 0.01 | 0.5 | 0.5 | 0.01 | 0.5 | |
| r | 1 | 1 | 1 | 1 | 1 | 1 | 1 | 1 | 1 | 1 | 1 | 1 | 1 | 1 | 1 | 1 |
Publisher’s Note: MDPI stays neutral with regard to jurisdictional claims in published maps and institutional affiliations. |
© 2022 by the authors. Licensee MDPI, Basel, Switzerland. This article is an open access article distributed under the terms and conditions of the Creative Commons Attribution (CC BY) license (https://creativecommons.org/licenses/by/4.0/).
Share and Cite
Aazza, M.; Mounir, C.; Ahlafi, H.; Moussout, H.; Bouymajane, A.; Chroho, M.; Giarratana, F.; Nalbone, L.; Cacciola, F. Study of the Effectiveness of Alumina and HDTMA/Alumina Composite in the Removal of Para-Nitrophenol and the Deactivation of Bacterial Effect of Listeria monocytogenes and Salmonella spp. Life 2022, 12, 1700. https://doi.org/10.3390/life12111700
Aazza M, Mounir C, Ahlafi H, Moussout H, Bouymajane A, Chroho M, Giarratana F, Nalbone L, Cacciola F. Study of the Effectiveness of Alumina and HDTMA/Alumina Composite in the Removal of Para-Nitrophenol and the Deactivation of Bacterial Effect of Listeria monocytogenes and Salmonella spp. Life. 2022; 12(11):1700. https://doi.org/10.3390/life12111700
Chicago/Turabian StyleAazza, Mustapha, Chadia Mounir, Hammou Ahlafi, Hamou Moussout, Aziz Bouymajane, Mounia Chroho, Filippo Giarratana, Luca Nalbone, and Francesco Cacciola. 2022. "Study of the Effectiveness of Alumina and HDTMA/Alumina Composite in the Removal of Para-Nitrophenol and the Deactivation of Bacterial Effect of Listeria monocytogenes and Salmonella spp." Life 12, no. 11: 1700. https://doi.org/10.3390/life12111700
APA StyleAazza, M., Mounir, C., Ahlafi, H., Moussout, H., Bouymajane, A., Chroho, M., Giarratana, F., Nalbone, L., & Cacciola, F. (2022). Study of the Effectiveness of Alumina and HDTMA/Alumina Composite in the Removal of Para-Nitrophenol and the Deactivation of Bacterial Effect of Listeria monocytogenes and Salmonella spp. Life, 12(11), 1700. https://doi.org/10.3390/life12111700

